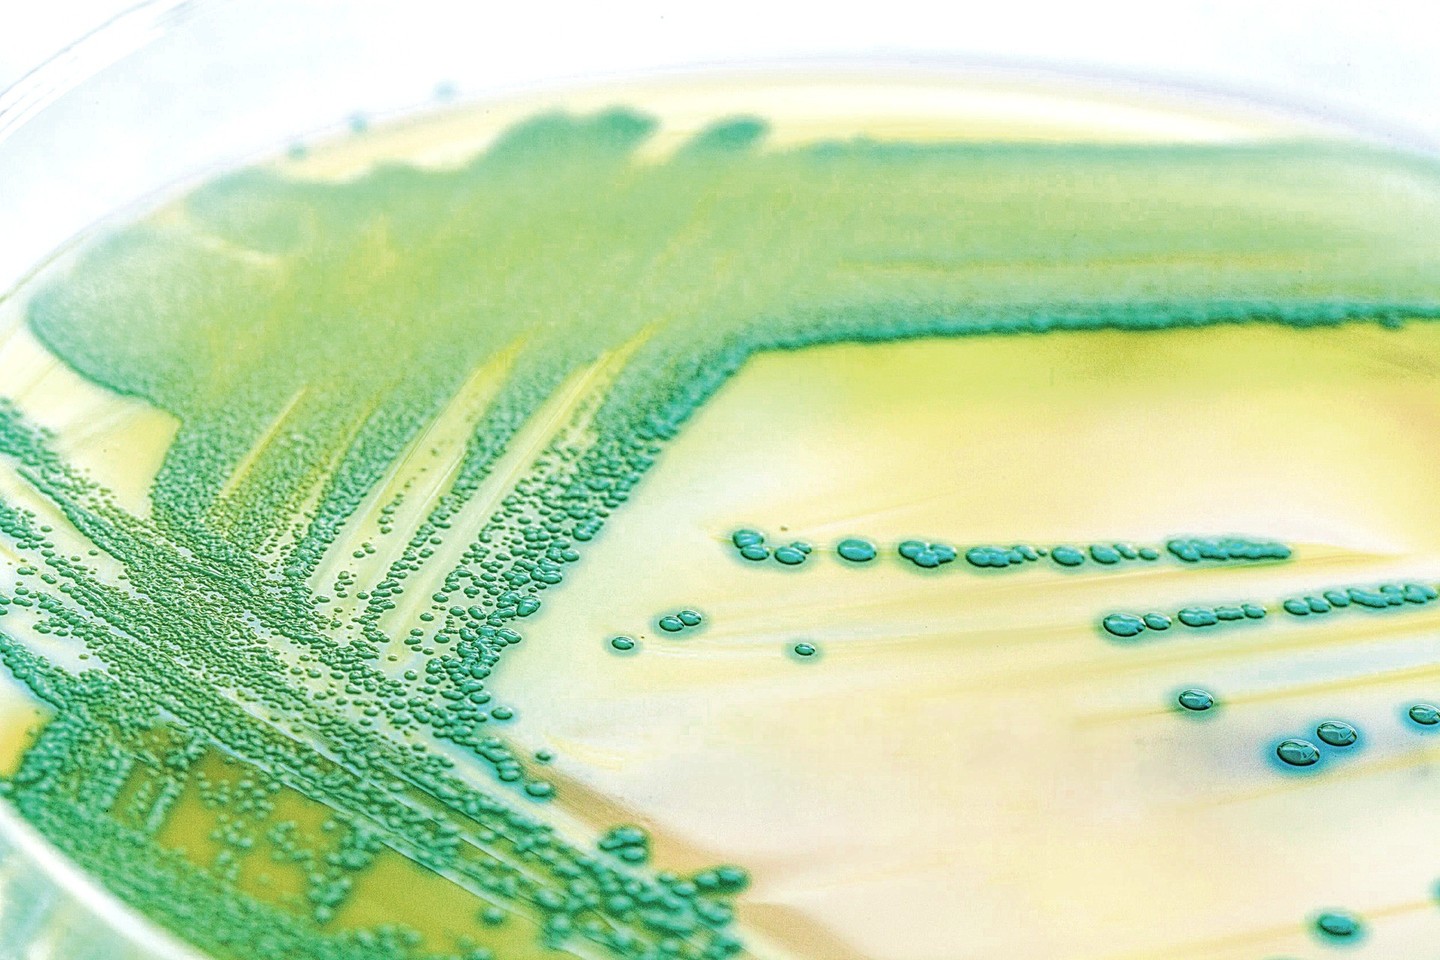

Bakterijų evoliucija tokia sparti, kad pokyčiai per trumpą laiką matomi plika akimi.
Bakterijos lyg niekur nieko prisitaiko prie aplinkos, kuri akimirksniu jas turėtų sunaikinti, ir joje tiesiog klesti.
Eksperimente matyti didžiulė petri lėkštelė, pripildyta keturiolika litrų agaro – natūralių dumblių pagrindu pagamintos terpės, ant kurios laboratorijose įprastai auginamos bakterijų kultūros.
Indas buvo padalintas į keletą sekcijų su skirtingomis antibiotikų dozėmis.
Atokiausiose indo dalyse antibiotikų visai nebuvo.
Tuo metu dalyse arčiau centro antibiotikų buvo tik šiek tiek daugiau nei minimali dozė, reikalinga bakterijoms žūti.
Kiekvienoje kitoje sekcijoje link centro antibiotikų dozė kaskart po dešimt kartų buvo vis didinama. Pačiame centre dozė buvo lygiai 1 tūkstantį kartų didesnė nei sekcijoje su mažiausia antibiotikų doze.
Tyrimo metu ant terpės buvo pasėtos E.coli bakterijos, o vaizdo kamera periodiškai registravo jų augimo ypatybes. Eksperimento tikslas buvo aiškiai pademonstruoti, kaip bakterijos tampa atsparios antibiotikams, ir leisti visuomenei suprasti, kokia tai svarbi problema.
Vyriausiasis tyrimą koordinavęs mokslininkas prieš keletą metų buvo matęs filmą, kuriame buvo vaizduojamas mirtinos virusinės pandemijos plitimas.
Tada ir kilo idėja sukurti šį vizualinį eksperimentą.
Vaizdo įraše matoma, kaip bakterijos, pasėtos ant mitybinės terpės krašto be antibiotikų, staiga ima greitai dalytis, o jų kolonija – plėstis.
Susiję straipsniai
Daugėjant bakterijų, dalis jų pasiekia terpės dalį su nedidele antibiotikų doze. Blogiausiai prisitaikiusių bakterijų dalis iškart žūsta, o toliau dalijasi tik bakterijos, pasižyminčios pranašesniais antimikrobiniais veiksniais.
Kaskart pasiekus vis kitą indo zoną su vis didesne antibiotikų koncentracija vyksta tas pat: bakterijos, kurios nesugeba prisitaikyti prie tokios aplinkos, iškart žūsta, nesidaugina arba dauginasi ypač lėtai, o išlieka ir toliau dauginasi tik geriausiai prisitaikiusios bakterijos.
Tokiu būdu per keletą bakterijų kartų bakterijos dauginasi labai sparčiai, o E.coli bakterija gali daugintis kas dvidešimt minučių – kaupiasi atsparumą lemiančios mutacijos.
Ir visa tai vyksta sukrečiamai sparčiai, o dozės, atsparumą kurioms bakterijos pasiekia, apskritai priverčia nuleisti rankas.
Mokslininkai pateikė ciprofloksacino pavyzdį. Bakterijos sugebėjo per keliolika kartų pasiekti tokį atsparumą ir augti net ant 100 tūkstančių kartų didesnės šio antibiotiko dozės nei pradiniame augimo etape.
Ką visa tai reiškia? Ogi tai, kad lygiai tas pat, tik gal ne taip sparčiai, vyksta ir realiame gyvenime. Daugėja vaistams atsparių ligų.
Jau dabar ne vienas antibiotikas laikomas visiškai neveiksmingu ir todėl nebenaudojamas.
Net spėjama, kad gyvensime taip, kaip gyvenome iki antibiotikų atsiradimo. O tada gimdymo metu mirdavo penkios moterys iš tūkstančio.
Susiję straipsniai
Kas devintas mirdavo dėl bet kokios infekcijos, kurią buvo galima pasigauti net dėl menkiausio įbrėžimo ar vabzdžio įkandimo.
Mirdavo trečdalis žmonių, užsikrėtusių pneumonija. Infekcinės ausų ligos baigdavosi kurtumu, o angina galėjo baigtis infarktu.
Situaciją galima gelbėti skatinant veterinarijos gydytojų (didžioji dalis pasaulyje pagaminamų antibiotikų panaudojama gyvūnams), medicinos personalo ir visos visuomenės supratingumą, atsakomybę ir gyventojų vartojimo įpročius.
Neretai antibiotikai skiriami profilaktiškai netgi neįsitikinus, ar ligą apskritai sukėlė bakterija. Tokiu atveju vaisto efektas lygus nuliui, tačiau jis kaskart juntamai paskatina antimikrobinio atsparumo plitimą.
Taip pat vertėtų mąstyti apie naujų antibiotikų kūrimo finansavimą, nes šiuo metu dėl pinigų trūkumo jie paprasčiausiai nekuriami.
Situaciją galima spręsti, tačiau pirmiausia reikia suprasti, kokia yra problema.
Galime tik tikėtis, kad eksperimento autoriams pavyko ją perteikti.
„Science“, LR